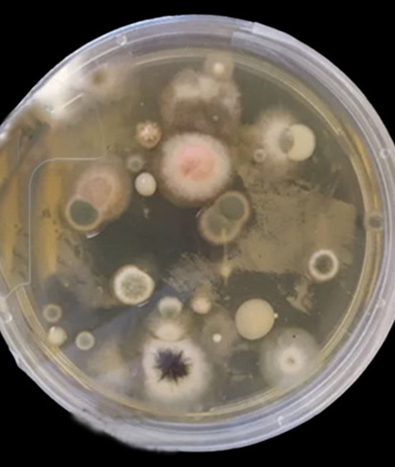
SabDex plate exposed to the air after incubation

Research
Current 2025 research and previous research can be found below:
Valley Fever

What do you think causes valley fever?
- Detection of Coccidioides in dust samples from Kern County, CA, using marble dust collectors and a nested PCR approach.
A collaboration with Drs. Reena Lamichane Khadka and Eduardo Merino, California Health Sciences University, College of Osteopathic Medicine, 2500 Alluvial Avenue, Clovis, CA 93611, US funded by the Valley Fever Americas Foundation and HSU Clovis
Methods to detect Coccidioides, the causative agent of Valley fever, in soil samples using molecular tools is widely established in clinical and environmental laboratories. However, detecting the pathogen in dust samples has remained a challenge. In this project, we use a dust collection method that allows the accumulation of amounts of dust that are sufficient for the reliable detection of microbial pathogens. This method has been tested successfully at CSUB in an Environmental Microbiology classroom setting previously over two semester periods. In a collaboration with the California Health Sciences University (CHSU) in Clovis, CA, we are investigating 4 locations in the Bakersfield (Kern County) area and an additional 4 locations around Clovis (Fresno County) over a one-year period for the presence of Coccidioides in dust samples. Students from CSUB and CHSU will be highly involved in sample collection, processing, and analysis supporting the education of future health care professionals to become educated on the topic of Valley fever in those counties which are traditionally known to have the highest incidence of coccidioidomycosis in California.

Coccidioides posadasii strain Δ chs5 growing on SabDex medium.

Marble dust collector outside Science 1 Building at CSUB.
Resistance of environmental fungi to azole drugs that are being used to treat coccidioidomycosis and other fungal diseases
A project funded by the National Institute of Food and Agriculture (NIFA) "SUPERSTAR" program, a USDA Research and Extension Experiences for Undergraduates (REEU) initiative, Grant # 2022-68018-36609
Coccidioidomycosis, also known as Valley fever, is an orphan disease, endemic to the arid regions of the Southwestern U.S. The disease is often misdiagnosed, delaying treatment with antifungal agents in the early stages of the disease, which has led to the dissemination of the disease in many patients. In addition, the increasing use of fungicides in the agricultural hub of the Central Valley of California to fight plant pathogens, has led to concerns about opportunistic fungal pathogens to develop resistance against these agents. In this study, we found that a large percentage of fungal isolates obtained from the air in Bakersfield, Kern County, CA, show strong resistance against four different azole drugs, namely Fluconazole, Itraconazole, Voriconazole, and Posaconazole, that are used to treat fungal infections including Valley fever in humans and animals. Especially Fluconazole, one of the most commonly used azole drugs prescribed for treatment, showed no or only minimal effect against most fungal isolates in contrast to Posaconazole which strongly reduced fungal mycelium growth of most isolates in azole challenge assays on Sabouraud Dextrose medium. This result was statistically significant. Results of this study are concerning in times where Valley fever incidence is increasing due to increased soil disturbance and climate change. This work will continue by including one of the newest azole drugs, Isavuconazole and different azole fungicides. Finally, we will also investigate mechanisms of resistance. More soon!
Example of a SabDex plate exposed to the air after incubation for one week at room temperature, showing diverse fungal colonies.

Bar plot showing the average growth (%) of fungal isolates exposed to four different azole drugs compared to growth on the control plates without any azole drug. A One-Way ANOVA showed a significant difference between the drugs in affecting mycelium growth (p < 0.05), meaning the average reduction of growth (%) are not the same. Because p < 0.05, we reject the null hypothesis and conclude that the drugs differ in efficiency regarding fungal mycelium growth.
- Detection of Coccidioides in dust samples from Kern County – Educating K-12 students on the topic of Valley fever
An ongoing collaboration between CSUB (Teacher Education and Biology) and the Kern High School District since 2021
K-12 educators and students will be educated on the endemic fungal pathogen Coccidioides, the causative agent of Valley fever in California by learning about the ecology of the pathogen as well as learning about methods to detect the pathogen in dust samples near their homes. K-12 science teachers and students will be involved in collecting dust samples throughout Kern County over the seasons from selected sites. After analysis for the presence of the fungal pathogen Coccidioides at CSUB, involving undergraduate Biology Majors, a rigid dataset will be produced that can then be evaluated in a Biology or Health Science K-12 course. Interested Citizen Science and K-12 teachers can learn the culture independent, molecular methods that are being used to detect the pathogen in a Biosafety 2 Microbiology Laboratory at CSUB.

Workshop for students at Stockdale High School on how to extract DNA from dust samples and how to perform PCRs to detect Coccidioides, June 2021.
San Joaquin Kit Fox


- Detecting the presence of the endangered San Joaquin Kit Foxes (SJKF) (Vulpes macrotis mutica) and other mammalian predators in Kern County, CA, using a non-invasive PCR-based method
This project is supported by CSUB’s Office of the Provost
Urban sprawl and change in land use led to a dramatic loss of habitat and population decline of the endangered, SJKF (Vulpes macrotis mutica). Essential to the protection of existing populations of this fox species and to prevent further destruction of suitable habitat that allows the mixing of otherwise isolated populations, the presence of SJKFs needs to be confirmed in the environment and reported to urban planning decision makers. We propose using a non-invasive method based on DNA extraction from scat collected in the field, followed by a diagnostic Polymerase Chain Reaction (PCR) that allows the distinction of different species of canine predators, including different fox species, from coyote, wolf, and dog. This method is less time intensive costly compared to traditional methods, such as cameras and trapping that are commonly used. A second PCR method that we propose will allow us to determine the diet of SJKF by using DNA extracted from scat and specific primer pairs for plants, insects, and animals. Communicating these methods to local environmental consultants may help to improve future environmental surveys for SJKF populations, to preserve suitable habitat for this canine species and to assess diversity and use of natural food sources.

Attending the Sierra Club Breakfast Talk about San Joaquin Kit foxes by Erica Kelly at Hodel’s Country Dining in early 2025.

Presenting kit fox research at the Western Society of Naturalists meeting in Portland, OR in 2024.
- Kit Fox conservation – developing a habitat conservation plan along the Kern River floodplains that connects isolated populations of the endangered San Joaquin Kit Fox (Vulpes macrotis mutica)
This project is supported by the National Wildlife Foundation and the Omaha Mutual Animal Kingdom
This project has two main goals that contribute to the protection of the endangered San Joaquin Kit Fox (SJKF) (Vulpes macrotis mutica) on the California State University Bakersfield (CSUB) campus and beyond. Over an 8-month period, we will conduct a survey on the SJKF on campus grounds and in nearby lower Kern River floodplain areas, using a non-invasive DNA based technology, established in our lab. A survey that identifies preferred denning and hunting grounds on campus and in areas along the Kern River that runs through the entire city and that connects fragmented fox populations, will support conservation strategies for this small canine species that has lost more than 90% of its original habitat in the San Joaquin Valley of California due to urban sprawl and extensive industrial agriculture. No other CSU campus has been recognized for having an endangered fox species roaming on its grounds. This fact is exciting but also comes with challenges. The survey data will be used for the development of a SJKF habitat conservation plan that will be presented to the CSUB administration and to the Bakersfield City Council. A habitat conservation plan is desperately needed due to increased fragmentation and separation of the remaining SJKF populations in and around urban Bakersfield. Some populations of SJKFs have adapted to living in urban areas, such as campuses, golf courses, school yards etc., among them the CSUB campus. Those locations provide additional food sources and may also provide protection against predators, such as coyotes (Canis latrans) or bobcats (Lynx rufus) which are known to kill smaller competitors. Research on SJKF on campus grounds has been included in the research portfolio of several CSUB faculties over time and provided research opportunities for many students in collaboration with the Endangered Species Recovery Program associated with CSU Stanislaus. However, even though we have increased our knowledge on the campus SJKF population, its long-term protection is not guaranteed. Almost 50% of the CSUB campus currently consists of disturbed semi-natural grassland, as well as irrigated grassland, mainly sport fields that SJKF use to hunt and den. In the ratified 2019-2024 CSUB Strategic Plan that will be re-visited in 2025, protection of endangered species such as the SJKF is not included. In the campus Master Plan, that was revised in 2024, almost all property is destined for future development which will reduce hunting and denning opportunities for SJKF significantly. Concerned faculty, staff, and students proposed to include long-term protection of the SJKF in a new land use plan to be incorporated in an updated CSUB Master Plan. An Ecosystem Council was formed on our campus in 2024 that includes representatives from different programs, campus police, students, faculties and administrators.

Examples of kit fox scat.

Examples of PCR results using primers specific to canines and other mammals.
CSUB Landscaping
- Building and managing a pollinator garden for native insects, including the Monarch Butterfly (Danaus plexippus)
This project is supported by CSUB.
Traditionally the landscape on the CSUB campus has not included many California native plant species. Different opinions on aesthetics about what is a beautiful landscape, as well as a misconception of an increase in maintenance that may result from landscaping with native plants that provide ecological value have resulted in the type of landscape that dominates the CSUB campus. The current landscaping and the extensive use of herbicides have resulted in a reduced biodiversity of plants, insects, birds, and other wildlife. In addition, many trees and shrubs that are commonly seen at CSUB are not native to the Southern San Joaquin Valley, many of them are not even drought tolerant. An area east of the campus, close to student housing was selected as a butterfly garden to support milkweed (Asclepias fascicularis) and the monarch butterfly (Danaus plexippus), whose populations have declined significantly over the last decades (US Fish & Wildlife Service, 2023a). About 60 milkweed plugs were obtained from Monarch Watch (Monarch Watch, 2023) for free and planted in the garden during the beginning of the spring semester 2023 with support of students, facility workers, and faculty. A map was designed that included suggestions of many California native plant species to be included in the garden (perennials, shrubs, trees, and cacti) (Figure 1). The garden is a work in progress, and we hope that with the diversity of plants chosen, we will provide an ecosystem for many pollinators including the Monarch butterfly. This project is now in its 4th year.

Growing CA native plants in the CSUB greenhouse (spring 2024).

Monarch butterfly visiting a Salvia sp. at the Butterfly Garden, June 2025.
- Turf-Lawn Replacement at CSUB with California Native Perennial Grasses and wildflowers
This project is supported by CSUB-Environmental Studies Areas (ESA)
Several species of California native bunchgrasses, sedges, and wildflowers were selected for a turf-grass replacement project on the CSUB campus using 2 different designs with the aim of adding ecological value to the landscape, increasing biodiversity, as well as contributing to long-term water conservation on campus. A site at the Environmental Studies Area (ESA) (312 m2) was chosen, prepared, and separated into several smaller plots that differed in plant diversity and in the amount of irrigation. In addition to monitoring growth of all plants over time under different irrigation management, students will investigate if the selected plants are able to form a meadow, tolerate the Bakersfield climate, in comparison to established turf-lawns (reference site on campus). This project started in the fall of 2023 with support from a CES-Minigrant to support 2 undergraduate student researchers. To continue this project, additional funding is needed for site monitoring, data collection and analysis, and overall maintenance. The aim of this project is to educate the campus community and the community of the City of Bakersfield to consider a suitable alternative to traditional turf-lawn and to identify those plants that are performing best.
Research plot at the ESA with different CA native grass species, some in cages to
protect from rodents, spring 2025.